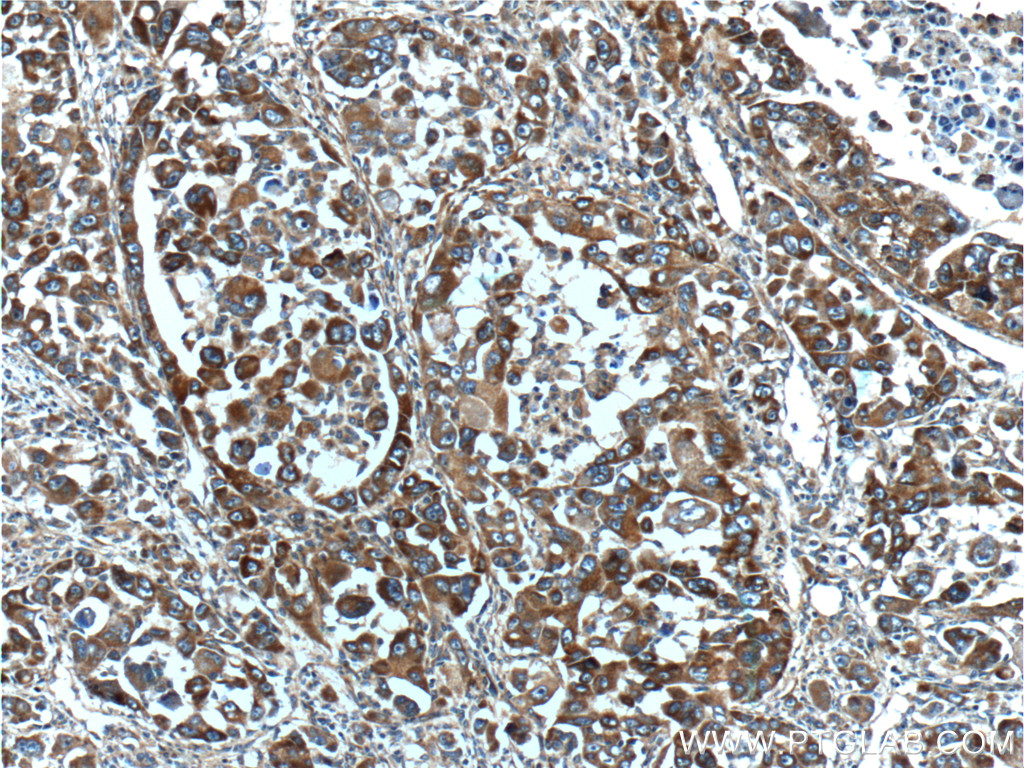

验证数据展示
经过测试的应用
| Positive WB detected in | mouse liver tissue, rat liver tissue |
| Positive IHC detected in | human liver cancer tissue, human liver tissue Note: suggested antigen retrieval with TE buffer pH 9.0; (*) Alternatively, antigen retrieval may be performed with citrate buffer pH 6.0 |
| Positive IF/ICC detected in | A431 cells |
推荐稀释比
| 应用 | 推荐稀释比 |
|---|---|
| Western Blot (WB) | WB : 1:500-1:1000 |
| Immunohistochemistry (IHC) | IHC : 1:100-1:400 |
| Immunofluorescence (IF)/ICC | IF/ICC : 1:50-1:500 |
| It is recommended that this reagent should be titrated in each testing system to obtain optimal results. | |
| Sample-dependent, Check data in validation data gallery. | |
产品信息
15880-1-AP targets TDO2 in WB, IHC, IF/ICC, ELISA applications and shows reactivity with human, mouse, rat samples.
| 经测试应用 | WB, IHC, IF/ICC, ELISA Application Description |
| 文献引用应用 | WB, IHC, IF |
| 经测试反应性 | human, mouse, rat |
| 文献引用反应性 | human, mouse, rat, chicken |
| 免疫原 |
CatNo: Ag8642 Product name: Recombinant human TDO2 protein Source: e coli.-derived, PET28a Tag: 6*His Domain: 55-406 aa of BC005355 Sequence: QELQSETKGNKIHDEHLFIITHQAYELWFKQILWELDSVREIFQNGHVRDERNMLKVVSRMHRVSVILKLLVQQFSILETMTALDFNDFREYLSPASGFQSLQFRLLENKIGVLQNMRVPYNRRHYRDNFKGEENELLLKSEQEKTLLELVEAWLERTPGLEPHGFNFWGKLEKNITRGLEEEFIRIQAKEESEEKEEQVAEFQKQKEVLLSLFDEKRHEHLLSKGERRLSYRALQGALMIYFYREEPRFQVPFQLLTSLMDIDSLMTKWRYNHVCMVHRMLGSKAGTGGSSGYHYLRSTVSDRYKVFVDLFNLSTYLIPRHWIPKMNPTIHKFLYTAEYCDSSYFSSDESD 种属同源性预测 |
| 宿主/亚型 | Rabbit / IgG |
| 抗体类别 | Polyclonal |
| 产品类型 | Antibody |
| 全称 | tryptophan 2,3-dioxygenase |
| 别名 | Tryptamin 2,3 dioxygenase, TRPO, TPH2, TO, TDO |
| 计算分子量 | 406 aa, 48 kDa |
| 观测分子量 | 40-50 kDa |
| GenBank蛋白编号 | BC005355 |
| 基因名称 | TDO2 |
| Gene ID (NCBI) | 6999 |
| RRID | AB_2827610 |
| 偶联类型 | Unconjugated |
| 形式 | Liquid |
| 纯化方式 | Antigen affinity purification |
| UNIPROT ID | P48775 |
| 储存缓冲液 | PBS with 0.02% sodium azide and 50% glycerol, pH 7.3. |
| 储存条件 | Store at -20°C. Stable for one year after shipment. Aliquoting is unnecessary for -20oC storage. |
背景介绍
TDO2 (tryptophan 2,3-dioxygenase), IDO1 (indoleamine 2,3-dioxygenase 1) and IDO2 are three enzymes that catalyze the amino acid tryptophan into kynurenine in the kynurenine pathway (PMID: 23090118, 28469468). TDO2 plays an important role in neurological diseases such as Alzheimer's disease, Parkinson's disease and autism. Overexpression of TDO2 promoted tumor cell survival and was correlated with tumor grade and poor prognosis in triple negative breast cancer, brain tumors and esophageal squamous cell carcinoma. TDO2 may be a potential therapeutic target in some cancers. (PMID: 21976023, 30134247)
实验方案
| Product Specific Protocols | |
|---|---|
| IF protocol for TDO2 antibody 15880-1-AP | Download protocol |
| IHC protocol for TDO2 antibody 15880-1-AP | Download protocol |
| WB protocol for TDO2 antibody 15880-1-AP | Download protocol |
| Standard Protocols | |
|---|---|
| Click here to view our Standard Protocols |
发表文章
| Species | Application | Title |
|---|---|---|
Cancer Cell Inhibition of De Novo NAD(+) Synthesis by Oncogenic URI Causes Liver Tumorigenesis through DNA Damage.
| ||
Nat Commun Engineered MED12 mutations drive leiomyoma-like transcriptional and metabolic programs by altering the 3D genome compartmentalization | ||
ACS Appl Mater Interfaces Reprogrammed IDO-Induced Immunosuppressive Microenvironment Synergizes with Immunogenic Magnetothermodynamics for Improved Cancer Therapy | ||
Br J Pharmacol Tryptophan 2,3-dioxygenase 2 plays a key role in regulating the activation of fibroblast-like synoviocytes in autoimmune arthritis.
| ||
Front Immunol DSS-induced colitis activates the kynurenine pathway in serum and brain by affecting IDO-1 and gut microbiota | ||